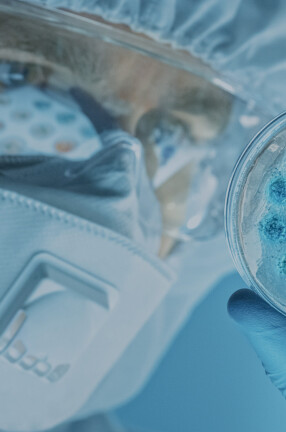
Quality 2000px BlueOverlay

Breathe Easy
We help you Breathe Easy by management of your controlled air environments and assets. From Conception and design to management, servicing and decommissioning.

Who we are
We are an accredited company specialising in supporting semiconductor, pharmaceutical, healthcare and HVAC facilities to manage, maintain and certify critical assets and controlled environments.
Our team are industry-leading experts who implicitly understand the risks you manage each day. It’s in our DNA.
We hold ourselves accountable to the highest standards while completing various services for our clients. In addition to our ISO 17025 accreditation, we remain committed to industry partnerships and the sustainable environments we manage for clients across multiple sectors.
What We Believe In
Make a Booking
How can we help?